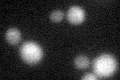
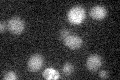

View description
Protein of unknown function, copurifies with late Golgi vesicles containing the v-SNARE Tlg2p
Localization:
Intensity:
Fold change:
Significance:
-
C’ GFP library in SD

below threshold15.93 -
N' NOP1pr-GFP in SD

punctate,vacuole54.6852 -
N' TEF2pr-mCherry in SD

vacuole65.9513 -
N' NATIVEpr-GFP in SD

punctate26.524 -
N' TEF2pr-VC and Cyto-VN in SD

#N/A0 -
C’ GFP library in SD+DTT
cytosol14.270.89No -
C’ GFP library in SD+H2O2

cytosol16.511.03No -
C’ GFP library in Starvation Media
cytosol181.12No -
C’ GFP library on the background of Pup2-DaMP

below threshold -
C’ GFP library on the background of CCT mutant

below threshold14.59790.915728No
